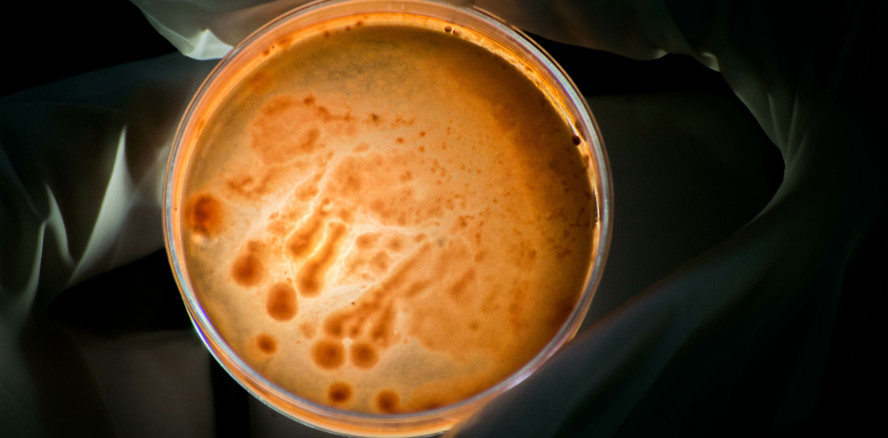
Coronavirus in bakteriellem Zahnbelag identifiziert

Wissenschaft und Forschung 06.05.2021
Coronavirus in bakteriellem Zahnbelag identifiziert
share
Brasilianische Wissenschaftler untersuchten in einer Studie das Vorhandensein des Virus SARS-CoV-2 in dentalem Biofilm von symptomatischen COVID-19-Patienten.
Eine in Brasilien durchgeführte Studie bestätigte das Vorhandensein des Coronavirus im dentalen Biofilm. Das Ergebnis bringt neue Perspektiven für das Verständnis der verschiedenen Wege, auf denen das Virus in den menschlichen Körper gelangt.
Die klinische Beobachtungsstudie bezog sich auf Personen mit grippeähnlichen Symptomen und wurde zwischen Juli und September 2020 durchgeführt. Ziel war es, das Vorhandensein von SARS-CoV-2-RNA im dentalen Biofilm von symptomatischen Patienten zu untersuchen, die in nasopharyngealen und oropharyngealen (NASO/ORO) Proben positiv getestet wurden. SARS-CoV-2-RNA wurde dazu von verschiedenen Stellen im Körper, einschließlich des Mundes, gewonnen.
Konkret wurden bei der Untersuchung Proben von 70 Personen analysiert, die positiv auf COVID-19 getestet wurden. In 19 % dieser Fälle wurde das Coronavirus auch im dentalen Biofilm nachgewiesen, und zwar genau bei den Teilnehmern, die in den oro- und nasopharyngealen Proben die höchste Viruslast aufwiesen. Als Quintessenz ergibt sich daraus die Schlussfolgerung, dass dentale Biofilme von symptomatischen COVID-19-Patienten SARS-CoV-2-RNA beherbergen und eine wesentliche Rolle bei der COVID-19-Übertragung spielen könnten.
Der Artikel „Dental biofilm of symptomatic COVID-19 patients harbors SARS-CoV-2“ wird im Journal of Clinical Periodontology veröffentlicht und ist von Sabrina Carvalho Gomes, Sabrina Fachin, Juliane Gonçalves da Fonseca, Patrícia Daniela Melchiors Angst, Marcelo Lazzaron Lamers, Ilma Simoni Brum da Silva und Luciana Neves Nunes verfasst.
Quelle: onlinelibrary.wiley.com